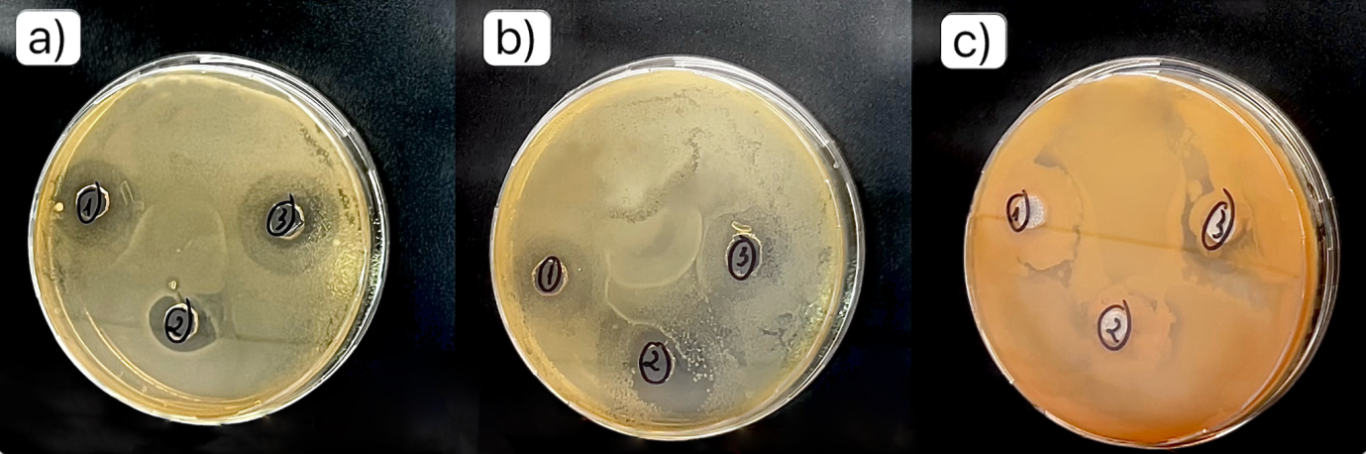
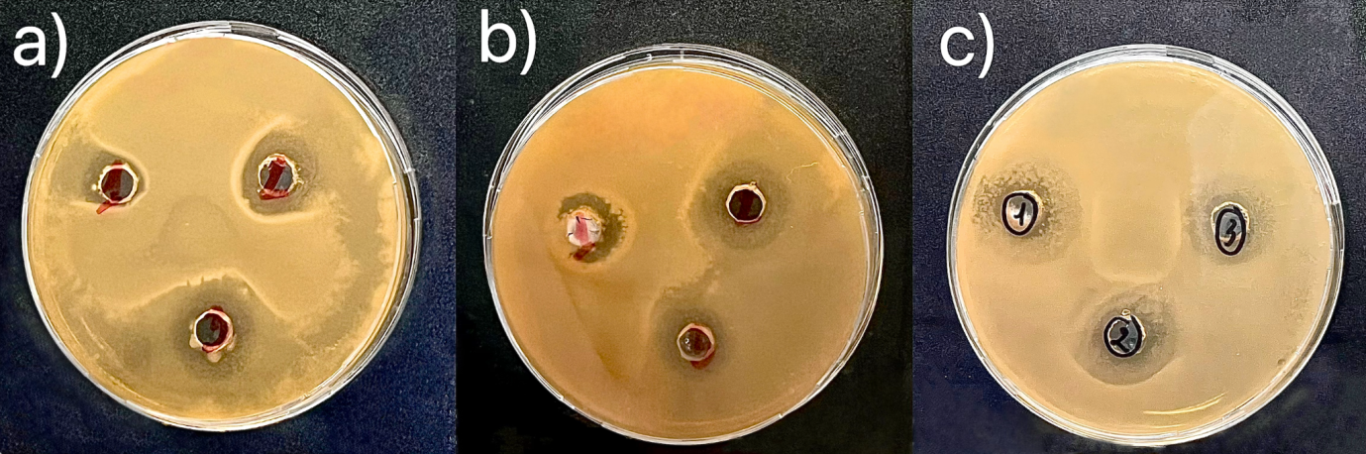

05/11/2025
Abstract
The growing environmental burden of plastic waste highlights the urgent need for sustainable alternatives in food packaging. Chitosan, a natural polymer derived from shrimp shell waste, offers excellent film-forming and biodegradable properties, while green tea extract (GTE) provides bioactive compounds with antibacterial activity. In this study, bioplastic films were prepared by blending chitosan with polyvinyl alcohol (PVA) and varying amounts of GTE (5, 7, and 10 mL). The biofilm synthesized with chitosan and green tea extract exhibited a smooth surface morphology, with tensile strength ranging from 12.51 ± 0.25 to 26.66 ± 0.53 MPa, elongation at break ranging from 388.3 ± 7.8% to 546.8 ± 10.9%, and can inhibit the growth of Escherichia coli (E. coli) bacteria. Incorporation of GTE reduced solubility, improved tensile strength, and enhanced antibacterial activity against Escherichia coli, with inhibition zones increasing proportionally with GTE content. Fourier transform infrared spectroscopy (FTIR) confirmed hydrogen bonding interactions between chitosan and phenolic compounds in GTE, while scanning electron microscopy (SEM) revealed uniform, compact surfaces. Biodegradability tests showed rapid degradation, with films losing over 90% of mass within 53 days. These findings suggest that chitosan–PVA–GTE films are promising eco-friendly packaging materials with improved mechanical durability, antibacterial functionality, and environmental sustainability.
Key words: Chitosan, shrimp shells, green tea extract, bioplastic films.
JEL Classification: Q53, Q55, L66.
Received: 2nd August 2025; Revised: 28th August 2025; Accepted: 16th September 2025.
1. INTRODUCTION
Plastic is one of the most widely used materials in the global economy, becoming indispensable in modern life with applications in packaging, medicine, and construction, etc. Currently, growing concern exists over the increasing global production of plastics. Plastic waste clogs drainage systems, canals and rivers, threatening marine and coastal ecosystems. This has negative impacts on important sectors of the economy, including tourism, shipping, and aquaculture (Franco-Trecu et al., 2017; Hermabessiere et al., 2017; Issac et al., 2021). In 2015, Vietnam generated about 5 million tons of plastic. In 2018, plastic production increased by 7%, reaching 8.3 million tons. Of the total processed plastic waste, nearly 12% of plastic is recovered or recycled, the rest is treated by incineration, landfill, or will leak into the environment (Ministry of Natural Resources and Environment, 2019). The majority of plastic comes from households (~70.4%), followed by markets (~16.9%) and other sources (Giang et al., 2023). Notably, the leakage into aquatic life accounts for 335 tons/year (~8.9%), mainly due to uncollected waste, poor trash and drainage systems, as well as waste spilled during transportation. A similar situation has been reported in major Vietnamese cities such as Ho Chi Minh City (11.3%), Da Nang (8.3%), and Quang Ninh (8.9%) (Tran et al., 2020) (Tran et al., 2020).
In order to address this issue, bioplastics were created in the beginning of the twenty-first century. Commercial polymer products made from natural or renewable resources are known as bioplastics (Rudin et al., 2013). Certain renewable materials derived from bioplastics may be regenerated through biological processes, and certain bioplastics are biodegradable under the right circumstances (Harnkarnsujarit et al., 2021). Vegetable oils, sugar, cellulose, proteins, and other natural and renewable materials are frequently utilized in the production of bioplastics. The manufacturing capacity of bioplastics was 1075 per 1000 tons in 2022, according to the European Bioplastics Association, and is predicted to rise to around 2453 per 1000 tons by 2024 (European Bioplastics, 2020). The need to switch from traditional plastics to bioplastics is growing as environmental conservation and protection become more widely recognized. About 1% of plastics produced worldwide each year are bioplastics, and current trends indicate that the market for bioplastics is expanding steadily across a range of sectors (Siracusa et al., 2020). Bioplastics are now widely used in many different industries due to their flexibility in design and the ability to improve material properties through the use of additives such as plasticizers, compatibilizers, cross-linkers and coupling agents to optimize thermo-mechanical performance, biodegradability and processability (extrusion, injection molding, blow molding, etc.) (Negrete-Bolagay & Guerrero, 2024). In addition, bioplastics are also used in the pharmaceutical and medical industries (biodegradable implants, bioactive films, drug delivery systems), construction and automotive (lightweight materials, non-load-bearing interior parts), coatings, adhesives and small electronic devices (Martínez et al., 2013).
Therefore, interest in bioplastic films has increased among consumers and the food industry due to growing environmental concerns along with concerns about the potential negative impacts of food packaging that will harm and poison human health, affect hormones causing endocrine disruption and cause some breast cancers (de Paula & Alves, 2024; Amato–Lourenço et al., 2021, Thoene et al., 2020). In addition, there is growing scientific evidence of the environmental friendliness and effectiveness of bioplastics in reducing the environmental impact (Kumar et al., 2024; Coppola et al., 2021; Dilkes–ho et al., 2019). Recently, many researches have been conducted on value–added products from seafood industrial waste such as chitin are being utilized to synthesize chitosan. Due to its affordable price, availability and diverse properties such as antibacterial activity, biodegradability, complexation, film–forming ability and good mechanical strength, chitosan stands out from other biopolymers, showing great potential in application as food packaging material (Priyadarshi & Rhim, 2020; Ahmed et al., 2025; Hasan et al., 2020). Along with the application of creating tensile films, to support the improvement of the mechanical strength of the product, chitosan is mixed with plasticizers such as PVA (Polyvinyl alcohol) and some additives. In addition, chitosan is also combined with some biological active substances in fruit peels, leaves, seeds, etc. to increase the antibacterial, antifungal and antioxidant properties of the film (Yun et al., 2021; Zhang et al., 2021). In this research, chitosan was combined with green tea leaf extract (GT), a compound with high antioxidant and antibacterial properties thanks to polyphenols in tea, to create a coating with effective antibacterial properties. Catechin is the predominant polyphenol in green tea, the antioxidant activity of which is a result of the neutralization of nitrogen and oxygen free radicals, as well as the ability to form complexes with metal ions in redox reactions (Musial et al., 2020). The specific chemical structure of polyphenols (presence of at least five hydroxyl groups) present in green tea has a significant impact on the antioxidant capacity (Koch et al., 2018). Tea Polyphenols (TPs) are non–toxic, antibacterial polymers that slow down the oxidation process and prevent the growth of bacteria in some foods (Liu, Liang et al., 2018; He et al., 2016).
This research highlights the importance of developing bioplastic films from chitosan extracted from shrimp shells, blended with PVA, as a sustainable alternative to conventional plastic packaging aligned with the UN Sustainable Development Goals (SDGs). A comprehensive characterization was conducted, including antibacterial activity, biodegradability, Fourier-transform infrared spectroscopy (FTIR), scanning electron microscopy (SEM), and mechanical testing. The results obtained from the study contribute to promoting orientation in the design and development of sustainable bio–packaging, while meeting urgent requirements related to environmental protection and ensuring food safety. In this article, the aim is to explore the potential of bio-waste (shrimp shells) as a renewable raw material in combination with green tea extract and its application in food preservation. The conversion of agricultural and aquatic waste into useful materials contributes to sustainable development strategies and a circular economy.
2. MATERIALS AND METHODS
2.1. Materials and chemicals
Waste shrimp shells were obtained from a local fish market in Ho Chi Minh city, Vietnam, and transported to the laboratory within one hour of collection. Upon arrival at the laboratory, shrimp shells scraped clean of loose tissue and washed individually in mild salt water to remove dirt and impurities. The shells are then dried at 70°C until crisp. Green tea leaves and nutrient agar were purchased from local supermarkets. Antimicrobial activity was assessed using Escherichia coli (ATCC25,922). All reagents, glycerol (C3H8O3 – 99%), acetic acid (C2H4O2 – 99.5%), LB Broth (Miller), and Polyvinyl alcohol (PVA) were supplied by commercial vendors (Ghtech, HiMedia Laboratories, and Sigma – Aldrich). All chemicals were used as received without further purification. Distilled water was used throughout the experiments.
2.1.1. Synthesis of Chitosan from chitin of Shrimp Shells (SS)
The chitin extraction procedure was adapted from Percot et al. (2024) with modifications to suit the experimental conditions.
Demineralization (DM)
Demineralization was conducted using HCl solution (2%) to remove inorganic salts (CaCO3, Ca3(PO4)2). Shrimp shells were soaked in HCl (ratio 1:12 w/v) at 30°C while stirring continuously for 1 hour (until no CO2 bubbles). Then, filtered, washed several times with distilled water. The resulting demineralized shrimp shells were washed until the pH was neutral (~7).
Deproteinization (DP)
The deproteinization process was performed to remove organic protein from demineralized shrimp shells. Shrimp shell protein was recovered by the classical deproteinization process on demineralized shrimp shells in NaOH solution (3.5%; washing in a 15:1 w/v solution layer) to ensure safety and no chitin hydrolysis. The NaOH solution was heated to 75°C, and the demineralized shells were soaked at a 1:10 w/v ratio and stirred for 3 hours. Finally, the product obtained was crude chitin after being filtered, washed with hot and cold water until the pH was neutral.
Decolorization
Prior to deacetylation, decolorization was performed to remove any pigments such as astaxanthin and melanin from the chitin. The following decolorization procedure is based on Iñiguez–Moreno et al., 2024; Xiong et al., 2023, but has been modified to be compatible with the experimental conditions. This procedure is performed by immersing the sample in a hydrogen peroxide solution H2O2 3% (v/v) for 25 min at 65°C. Finally, the sample was rinsed with distilled water to achieve neutral pH and then dried in an oven at 60°C for 24 hours.
Conversion of chitin to chitosan
The deacetylation of chitin to chitosan was carried out by hydrolysis of the acetyl groups using concentrated sodium hydroxide (NaOH, 40 wt%). The deacetylation vessel was refluxed at 100°C under ambient pressure for up to 40 hours; this reaction was accompanied by a vigorous decomposition of the chitin to produce chitosan (Ghanem et al., 2025; Al Sagheer et al., 2009). High concentrations should be used in a safe and suitable process to avoid polymer degradation.After deacetylation, the chitin was washed until neutral pH (pH = 7) was achieved, and then dried in a UN30 drying oven at 70°C for 4 hours (Sree et al., 2020). The crude chitosan obtained exhibited an ivory to light–yellow color.
Preparation of green tea extract
Green tea leaf extract was prepared based on the method of Yang, et al (Yang et al., 2022). Green tea leaves were heated for 10 minutes at 90ºC with a ratio of 2gr to 10mL of distilled water and filtered using Whatmann No.1 filter paper to obtain the extract. The extract was stored at 4ºC for the next experiment.
Manufacturing of Bioplastic
To prepare the film–forming solution, chitosan was dissolved in 2% (v/v) aqueous acetic acid and stirred for 4 hours. Polyvinyl alcohol (PVA) was dissolved separately in distilled water at 90°C under stirring at 250 rpm for 2 hours. Then, PVA solution was poured into chitosan solution and mixed using a magnetic stirrer at 250 rpm for 1 hour (Fadia Zatalini et al., 2023). Chitosan – PVA mixtures were prepared at weight ratios of 1:1, 1:3 and 3:1 (w/w), which would correspond to M11, M13, M31 films, respectively. After mixing, 0.5 mL of additives was added to each solution, followed by stirring for 15 min to obtain a homogeneous, thickened solution. Finally, the resulting mixtures were cast into Petri dishes, ensuring that no air bubbles remained on the surface, and then dried at 80°C for 3 hours.
Film formation process from chitosan and green tea
Green tea extract at a concentration of 10% was mixed with chitosan solution and poured into petri dishes. After drying in an oven at 45°C for 2 hours, the film was peeled off from the petri dish and stored in an airtight container at 23°C for further testing (Amankwaah et al., 2020).
Characteristics of Bioplastic
The bioplastic characteristic tests include film thickness, SEM, FTIR, film tensile strength, water solubility, testing antibacterial ability by agar hole punching method and biodegradation test.
2.1.2. Mechanical properties
Determination of film thickness and tensile strength (ASTM D882-18)
The mechanical properties of the bioplastic films such as film thickness and tensile strength at break were determined using a PTA MTC 500 Testing Machine (Spain) connected to a Registra3 software on the computer. Measurements were made with a 1000N force sensor, a 500 mm/min clamping speed and a 50 mm clamping distance. Five measurements were taken randomLy from two locations on each film. The average value from five measurements was reported.
Scanning electron microscopy (SEM)
Scanning Electron Microscopy (SEM) was employed to examine the surface morphology of the synthesized membrane using a Hitachi S–4800 FESEM with a magnification of 6000× at an accelerating voltage of 10 kV.
Fourier transform infrared spectroscopy (FTIR)
Fourier–transform infrared spectroscopy (FT–IR) served as the analytical method to investigate chemical bonds within composite sheets, employing a Frontier FT–IR/NIR spectrometer (PerkinElmer, serial number 105667). This state–of–the–art equipment facilitated high-resolution spectroscopy with a precision of 4 cm-1 , enabling detailed examination of molecular interactions and vibrations in the material. IR spectroscopy measurements spanning from 4000 cm-1 to 400 cm-1 allowed for a thorough analysis of functional groups, chemical compositions, and bonding configurations present in the bioplastic composite
Determination of solubility in water (%)
According to the method described by Rubilar et al, the water solubility of the film was determined. The solubility was defined as the dry mass fraction dissolved after 48 hours of immersion in water using the following equation (Rubilar et al., 2013):
Where Mi is the initial mass and Mf is the final mass (g) of the sample. Five replicates were taken for each sample.
Testing antibacterial ability by agar hole punching method
Chitosan film formulations containing green tea extract and Chitosan – PVA film mixtures were prepared at weight ratios of 1:1, 1:3 and 3:1 (w/w) were tested for antibacterial activity against Escherichia coli bacteria. The experiment was conducted by pipetting 100µl of the Escherichia coli bacteria solution into a petri dish containing LB agar under sterile conditions. Using a glass triangular inoculating rod, spread it evenly over the agar surface, then punch a hole and fill the hole with the sample solution. Incubate immediately at 37°C for bacteria to grow for 48 hours. Observe and measure the diameter of the sterile zone on the agar plate (Rai et al., 2017).
Determination of biodegradation time
The biodegradability of chitosan films was evaluated by soil burial method. For the soil burial test, film samples were buried to a depth of 9 cm in moist soil and then periodically removed weekly, washed, dried, and reweighed to determine the rate of mass loss over time (ASTM 5336).
3. RESULTS AND DISCUSION
3.1. Film thickness and water solubility
The appearance of packaging plays a crucial role in shaping consumers' perception of the contained food. The basic properties of the film including thickness (mm), water solubility (%) are shown in Table 1. Film thickness is an important parameter that determines the final physical, mechanical and barrier properties of biodegradable films. Thickness values ranged from 0.051 to 0.065 mm, with the green tea chitosan film had the thickest thickness of 0.065 mm. The film thickness under all conditions was not significantly different (p>0.05). This may be because the film thickness was controlled by a defined film solution volume and a constant diameter of the petri dish. In addition, film thickness is also influenced by the solid content of green tea extract (GTE). According to Kasai et al., the thickness of the film directly affects its mechanical strength and overall performance in packaging applications. These important factors for preserving the freshness and quality of perishable products require thicker films to provide a barrier against oxygen and moisture (Kasai et al., 2018). The incorporation of GTE into chitosan/PVA films improved the mechanical properties, thickness and water vapor barrier, enhanced the polyphenol content and antioxidant activity of the films (Siripatrawan & Harte, 2010). The appropriate thickness can prolong the shelf life of foods and maintain optimal conditions during storage and transportation. In addition, the thickness of the film also affects the puncture resistance and durability of the film, which are important during handling and transportation (Roy et al., 2023).
The water solubility values of different films were presented in Table 1. The results showed that the water solubility of the film decreases with the addition of green tea extract. In general, higher solubility indicated lower water resistance. Therefore, GTE film had higher water resistance as its water solubility is 54.2%. This may be due to the OH- groups of the phenolic compound in GTE forming H-bonds with the NH3+ groups of the chitosan backbone (Bourtoom and Chinnan, 2008; Siripatrawan and Harte, 2010). Stronger intermolecular H-bonds, between the OH- groups of GTE and the NH3+ groups of chitosan, reduced the affinity of the GTE film for water and led to a decrease in water solubility.
Table 1: The thickness and water solubility of the prepared films with different compositions.
|
Film samples |
Thickness (mm) |
Water Solubility (%) |
|
M11 |
0.051 |
95.08 |
|
M13 |
0.051 |
97.40 |
|
M31 |
0.052 |
89.15 |
|
GTE |
0.065 |
54.16 |
3.2. Tensile strength (TS) and Elongation at break (E)
Usually, the TS and E were desired properties for a packaging film to keep and maintain its integrity to tolerate external stress and tightness. The arrangement and compactness of the inter- and intra-molecular connections between polymer chains in the film structure usually determined the film's mechanical properties (Murugan et al., 2024). In general, high molecular weight PVA produced blend films with high tensile strength and low elongation at break. The TS and E of the prepared films were shown in Table 2. The mechanical properties of chitosan films incorporated with different ratios of Chitosan/PVA concentrations and GTE were statistically compared. The results showed that GTE significantly affected the mechanical resistance and extensibility of the chitosan-based films. As can be seen in Table 2, the TS of Chitosan/PVA blended films ranged from 12.50 to 26,66 MPa and the values increased with increasing PVA content. The M11 film exhibited a TS of 25.04 MPa and an E of 459.6%, respectively. In contrast, the M31 film decreased TS by 50% (12.51 MPa) but increased E sharply by 84% (546.8%). The TS and E of M13 film were 26.66 MPa and 388.3%, respectively. The addition of plasticizers such as glycerol and sorbitol has been reported to improve polymer flexibility. Cerqueira et al. created the plasticizers by looking at how adding glycerol/sorbitol affected them (Cerqueira et al., 2012). In general, high molecular weight PVA produces blend films with high tensile strength and low elongation at break. Adding the right amount of PVA to the films can make them stronger. Blending causes intermolecular interactions between the two polymers, which increases the mechanical strength of the blended film. Blending these two polymers improves their mechanical properties by interacting with their −OH and −NH2 groups. In fact, The mechanical strength of the film increases with increasing molecular weight and deacetylation of chitosan (Hajji et al., 2016).
The TS of the films increased as the GTE concentration increased. However, the E showed an opposite trend compared to TS, as shown in Table 2. The increase in TS value with increasing GTE content may be due to the formation of hydrogen bonds between OH- groups of polyphenolic molecules and NH3+ reactive groups of chitosan backbone. This interaction contributed to the enhanced strength of the films. When GTE was added, the E value decreased, indicating that the film became less flexible. The decrease in extensibility of the film may be the result of the restricted movement of the chain due to the interaction between chitosan and GTE (Detduangchan et al., 2014).
Table 2: The tensile strength and elongation at break of the prepared films with different compositions.
|
Film samples |
Tensile strength (MPa) |
Elongation (%) |
|
M11 |
25.02 |
459.6 |
|
M31 |
12.51 |
546.8 |
|
M13 |
26.66 |
388.3 |
|
GTE |
23.73 |
422 |
3.3. FTIR spectra results

Fig 1. Fourier-transform infrared spectroscopy analysis: a. Chitosan - PVA membrane, b. Chitosan - PVA membrane immersed in green tea extract
The characteristic peaks corresponding to the bending and stretching vibrations of functional groups in the synthesized chitosan–PVA film and the chitosan–PVA film immersed in green tea extract illustrate significant chemical interactions within these materials, as shown in Figure 1. The FTIR spectrum of the synthesized chitosan–PVA membrane displayed characteristic peaks, confirming the presence of functional groups from both polymers (Fig 1a). Broad absorptions at 3552–3430 cm⁻¹ were assigned to O–H and N–H stretching vibrations, indicating hydroxyl and amine groups capable of hydrogen bonding. Peaks at 2964 and 2910 cm⁻¹ corresponded to aliphatic C–H stretching, while a strong band at 1725 cm⁻¹ was attributed to C=O stretching from ester or carbonyl groups. The amide I (1643 cm⁻¹) and amide II (1549 cm⁻¹) bands reflected the characteristic vibrations of chitosan, and additional peaks between 1316 and 1087 cm⁻¹ were assigned to C–O stretching, confirming the presence of alcohol and ether functionalities in both chitosan and PVA (Jasrotia et al., 2025). After immersion in green tea extract, notable spectral changes were observed, indicating interactions between polyphenolic compounds and the Chitosan–PVA matrix (Fig 1b). The broad O–H/N–H stretching shifted to 3441 cm⁻¹, suggesting stronger hydrogen bonding due to the incorporation of tea polyphenols. New peaks at 3084–3027 cm⁻¹ appeared, corresponding to aromatic C–H stretching, while additional signals at 1619 and 1493 cm⁻¹ were associated with aromatic C=C skeletal vibrations, confirming the integration of green tea-derived aromatic compounds. Furthermore, C–O stretching bands at 1156–1029 cm⁻¹ were intensified, reflecting contributions from ether and alcohol groups in both the polymer and tea extract. The presence of low-wavenumber bands at 906–538 cm⁻¹ further supported aromatic skeletal vibrations from green tea constituents. Collectively, these findings demonstrate that immersion in green tea extract introduced new functional groups and enhanced hydrogen bonding, evidencing strong chemical interactions between the bioactive polyphenols and the chitosan–PVA membrane (Peng et al., 2013).
3.4. Scanning electron microscopy (SEM)
Fig 2. SEM micrographs of composite films: a. Chitosan – PVA 1:1 w/w, b. Chitosan – PVA 1:3 w/w, a. Chitosan – PVA 3:1 w/w, a. Chitosan – PVA 1:1 w/w with 7mL green tea extract
The morphology of the synthesized shrimp chitosan membranes at various chitosan – PVA compositions were studied using SEM techniques (Fig 2). The surface of the chitosan: PVA (1:1, w/w) membrane exhibited a relatively homogeneous and compact morphology with a fine nodular texture and a few isolated aggregates, indicating reasonable miscibility between the two polymers (Fig 2a). In contrast, the PVA–rich (1:3, w/w) membrane revealed pronounced phase separation, characterized by plate–like domains, sharp rims, and micro–fissures that are likely associated with crystallization of PVA during solvent evaporation (Fig 2b). Meanwhile, the chitosan–rich (3:1, w/w) membrane displayed a comparatively smooth and continuous surface matrix with minor ridges, suggesting improved structural uniformity. These observations highlight that the relative chitosan/PVA ratio governs the extent of phase separation and surface texture, with higher PVA contents favoring crystallization–induced heterogeneity and higher chitosan contents promoting a smoother, more uniform film structure (Fig 2c) (Le Ba Thai et al., 2024). Interestingly, the 1:1 w/w membrane after immersion in green tea extract exhibited a layered and striated surface pattern, distinct from the nodular morphology of the untreated film (Fig 2d) . This modification may be attributed to the adsorption and possible interaction of tea polyphenols with chitosan and PVA chains, which may alter hydrogen bonding and surface packing, thereby enhancing surface roughness and introducing a more ordered microstructure (Westlake et al., 2023).
3.5. Testing antibacterial ability by agar hole punching method
As shown in Figure 3, the pure Chitosan membrane was observed clear antibacterial ability against Escherichia coli strain. At a high Chitosan ratio (3:1 w/w), the inhibition zone reached 10 mm and 9 mm (Fig 3a), which was larger than that observed at a 1:1 w/w ratio (6 mm and 7 mm) (Fig 3b), indicating that higher chitosan content enhanced antibacterial effectiveness. In constract, at a 1:3 w/w ratio (lowest chitosan content), almost no inhibition zone was observed (Fig 3c), suggesting insufficient chitosan to exert antibacterial activity, thus allowing E. coli proliferation. When green tea extract (GTE) was incorporated into the chitosan membrane at concentrations of 5, 7, and 10 mL, the inhibition zones against E. coli were 12 mm (Fig 4a), 13 mm (Fig 4b) and 14 mm (Fig 4c) respectively. The analysis results show that when chitosan and green tea leaf extract are mixed to create a film with good antibacterial properties, this suggests that the synergy between chitosan and polyphenol compounds in green tea (such as catechin) significantly enhances antibacterial activity (Musial et al., 2020). Chitosan already has natural antibacterial properties, but the combination with green tea extract increased the effectiveness of inhibiting E. coli bacteria (Rahayu et al., 2022), opening up the potential application of Chitosan–green tea films in food packaging to prolong the preservation time and improve food safety and hygiene.
Fig 3. Image of measuring the diameter of the E. coli sterile zone of Chitosan – PVA film mixtures with scale bars of a) 3:1 w/w, b) 1:1 w/w, c) 1:3 w/w
Fig 4. Image of measuring the diameter of the E. coli sterile zone of Chitosan with green tea extract with scale bars of a) 5mL, b) 7mL, c) 10mL
3.6. Determination of biodegradation time
As mentioned earlier, biodegradable active packaging is the main focus of current food packaging research and development. Accordingly, the aim of this study is to develop an environmentally friendly active film from chitosan combined with aqueous green tea extract as a natural antioxidant. The possibility of improving the antioxidant properties of chitosan films is to combine with antioxidant agents (Muñoz-Tebar et al., 2023). The results of the biodegradation test in Table 3 and Fig 5 showed that each sample had a clear tendency to decrease in mass and there were significant differences at each time point. The Chitosan – PVA sample with a ratio of 1:3 w/w, M13, after 30 days, the mass decreased from the initial 0.1850g to 0.0740g, equivalent to 60% decomposition and only 0.0192g on day 53, reaching 89.62% decomposition. The Chitosan – PVA sample with a ratio of 1:1 w/w, M11, decreased from 0.1887g to 0.0813g after 30 days (56.92% decomposition) and 0.0203g after 53 days (89.24% decomposition). The Chitosan – PVA sample with a ratio of 3:1 w/w, M31, had a mass of 0.1916g, after 30 days had a decomposition rate of 53.5% (0.0891g) and decomposed to 88.67% in the next 23 days (remaining 0.0217g) Notably, the GTE sample had the highest initial mass of 0.1965g but after being buried in the ground, the sample mass decreased the fastest, only 0.0603g on day 30 (69.31% decomposition) and 0.0165g on day 53 (91.60% decomposition). This shows that the MGTE film showed the highest early decomposition rate but the largest decrease rate in the later phase, suggesting that as a good source of polyphenols, GTE can be used as an active agent and incorporated into the film. This biodegradability is due to cellulose and glycerol, which contain O–H groups that can bond together and are able to bind moisture from the air, helping them to degrade quickly (Mashuni et al., 2022). It can be concluded that the biodegradable plastic from Chitosan, PVA and GTE has met the standard because the biodegradation test met the international standard (ASTM 5336).
Table 3: Biodegradation time (days) and weight loss (g) survey of chitosan film
|
Time (days) |
Sample M13 (g) |
Sample M11 (g) |
Sample M31 (g) |
Sample GTE (g) |
|
0 |
0.1850 |
0.1887 |
0.1916 |
0.1965 |
|
30 |
0.074 |
0.0813 |
0.0891 |
0.0603 |
|
53 |
0.0192 |
0.0203 |
0.0217 |
0.0165 |

Fig 5. Biodegradation time and weight loss survey of chitosan film
4. CONCLUSION
This study indicated that an active film from chitosan-based film can be effectively developed through the incorporation of green tea extract (GTE) as a natural antioxidant. Addition of GTE improved high antioxidant and antibacterial properties thanks to polyphenols in tea, to create a coating with effective antibacterial properties. Catechin is the predominant polyphenol in green tea, the antioxidant activity of which is a result of the neutralization of nitrogen and oxygen free radicals, as well as the ability to form complexes with metal ions in redox reactions. These changes, as verified by FTIR analysis, could be attributed to the interactions between functional groups of chitosan and GTE polyphenolic compounds. To assess the overall performance of the films, comprehensive characterization was conducted, including SEM imaging, biodegradability testing, antibacterial assays, and mechanical evaluations. By simultaneously addressing food safety concerns and environmental protection requirements, the findings highlight the strong potential of chitosan–GTE films in guiding the design and development of sustainable bio-packaging solutions.
Acknowledgement: This research was funded by Ho Chi Minh City University of Technology, Vietnam National University under project number To-MTTN-2024-09 and SVOISPLV-2024-MT&TN – 48.
Phan Thanh Lâm1,2, Nguyễn Hồng Minh Thư1,2, Nguyễn Hoàng Thanh Vy 1,2,
Phan Thanh Kim Loan 1,2, Đặng Vũ Bích Hạnh1,2*
1 Ho Chi Minh City University of Technology (HCMUT)
2 Vietnam National University Ho Chi Minh City
(Source: The article was published on the Environment Magazine by English No. III/2025)
REFERENCES
1. Ahmed, H., Noyon, M. A. R., Uddin, M. E., Rafid, M. M., Hosen, M. S., & Layek, R. K. (2025). Development and Characterization of Chitosan–Based Antimicrobial Films: A Sustainable alternative to plastic packaging. Cleaner Chemical Engineering, 11, 100157. https://doi.org/10.1016/j.clce.2025.100157
2. Al Sagheer FA, Al–Sughayer MA, Muslim S, Elsabee MA. Extraction and characterization of Chitin and Chitosan from marine sources in Arabian Gulf. Carbohydr Polym. 2009;77:410–9. https://doi.org/10.1016/j.carbpol.2009.01.032.
3. Amankwaah, C., Li, J., Lee, J., & Pascall, M. A. (2020). Antimicrobial activity of chitosan‐based films enriched with green tea extracts on murine norovirus, Escherichia coli, and Listeria innocua. International Journal of Food Science, 2020(1), 3941924.
4. Amato–Lourenço, L. F., Carvalho–Oliveira, R., Júnior, G. R., dos Santos Galvão, L., Ando, R. A., & Mauad, T. (2021). Presence of airborne microplastics in human lung tissue. Journal of hazardous materials, 416, 126124.
5. Coppola, G., Gaudio, M.T., Lopresto, C.G. et al. Bioplastic from Renewable Biomass: A Facile Solution for a Greener Environment. Earth Syst Environ 5, 231–251 (2021). https://doi.org/10.1007/s41748–021–00208–7
6. Detduangchan, N., Sridach, W. and Wittaya, T. (2014) Enhancement of the properties of biodegradable rice starch films by using chemical crosslinking agents. International Food Research Journal 21(3): 1225–1235.
7. Dilkes–Hoffman, L. S., Lant, P. A., Laycock, B., & Pratt, S. (2019). The rate of biodegradation of PHA bioplastics in the marine environment: A meta–study. Marine Pollution Bulletin, 142, 15–24.
8. European Bioplastics. (2020). Bioplastic market development update 2020. In Proceedings of the European Bioplastics Conference, Berlin Online, 30 November–3 December 2020 (pp. 2019–2020).
9. Hajji, S., Chaker, A., Jridi, M., Maalej, H., Jellouli, K., Boufi, S., & Nasri, M. (2016). Structural analysis, and antioxidant and antibacterial properties of chitosan-poly (vinyl alcohol) biodegradable films. Environmental Science and Pollution Research, 23(15), 15310-15320.
10. Harnkarnsujarit, N.; Wongphan, P.; Chatkitanan, T.; Laorenza, Y.; Srisa, A. Bioplastic for Sustainable Food Packaging. In Sustainable Food Processing and Engineering Challenges; Elsevier: Amsterdam, The Netherlands, 2021; pp. 203–277.
11. Fadia Zatalini, D., Hendradi, E., Drake, P., & Sari, R. (2023). The effect of chitosan and polyvinyl alcohol combination on physical characteristics and mechanical properties of chitosan–PVA–Aloe vera film.
12. Franco-Trecu, V.; Drago, M.; Katz, H.; Machín, E.; Marín, Y. With the noose around the neck: Marine debris entangling otariid species. Environ. Pollut. 2017, 220, 985–989.
13. Ghanem, S. N., Marzouk, M. I., Tawfik, M. E., & Eskander, S. B. (2025). Spectroscopic approaches for structural analysis of extracted chitosan generated from chitin deacetylated for escalated periods. BMC chemistry, 19(1), 214.
14. Giang, N. B., Tuan, T. N., Tin, H. C., Chung, D. T., Ni, T. N. K., Binh, N. H., Nhung, D. T., Tuan, L. C., Son, T. M., & Khuyen, N. T. B. (2023). Current Plastic Waste Status and Its Leakage at Tam Giang–Cau Hai Lagoon System inCentral Vietnam. Urban Science, 7(3), 89. https://doi.org/10.3390/urbansci7030089
15. Hasan, M., Gopakumar, D. A., Olaiya, N., Zarlaida, F., Alfian, A., Aprinasari, C., Alfatah, T., Rizal, S., & Khalil, H. A. (2020). Evaluation of the thermomechanical properties and biodegradation of brown rice starch–based chitosan biodegradable composite films. International Journal of Biological Macromolecules, 156, 896–905. https://doi.org/10.1016/j.ijbiomac.2020.04.039
16. Hermabessiere, L.; Dehaut, A.; Paul-pont, I.; Lacroix, C.; Jezequel, R.; Soudant, P.; Du, G. Occurrence and effects of plastic additives on marine environments and organisms: A review. Chemosphere 2017, 182, 781–793.
17. Issac, M.N.; Kandasubramanian, B. Effect of microplastics in water and aquatic systems. Environ. Sci. Pollut. Res. 2021, 28, 19544–19562.
18. Iñiguez–Moreno, M., Santiesteban–Romero, B., Melchor–Martínez, E. M., Parra–Saldívar, R., & González–González, R. B. (2024). Valorization of fishery industry waste: Chitosan extraction and its application in the industry. MethodsX, 13, 102892. https://doi.org/10.1016/j.mex.2024.102892
19. Jasrotia, S., Gupta, S., Kudipady, M. L., & Puttaiahgowda, Y. M. (2025). Development and characterization of chitosan-PVA-tannic acid film for extended shelf life and safety of food products. ACS Omega, 10(19), 19361-19378. https://doi.org/10.1021/acsomega.4c09964
20. J.F. Rubilar, M.S.C. Rui, H.D. Silva, A.A. Vicente, I. Khmelinskii and M.C. Vieira, J. Food Engg., 115 (2013) 466–474.
21. Kumar, R., Lalnundiki, V., Shelare, S. D., Abhishek, G. J., Sharma, S., Sharma, D., ... & Abbas, M. (2024). An investigation of the environmental implications of bioplastics: Recent advancements on the development of environmentally friendly bioplastics solutions. Environmental research, 244, 117707.
22. Le Ba Thai, N., Beaman, H. T., Perlman, M., Obeng, E. E., Du, C., & Monroe, M. B. B. (2024). Chitosan poly(vinyl alcohol) methacrylate hydrogels for tissue engineering scaffolds. ACS Applied Bio Materials, 7(12), 7818-7827. https://doi.org/10.1021/acsabm.3c01209
23. Liu, Y., Liang, X., Wang, S., Qin, W., & Zhang, Q. (2018). Electrospun antimicrobial polylactic acid/tea polyphenol nanofibers for food–packaging applications. Polymers, 10(5), 561.
24. Martínez, I.; Partal, P.; García-Morales, M.; Guerrero, A.; Gallegos, C. Development of protein-based bioplastics with antimicrobial activity by thermo-mechanical processing. J. Food Eng. 2013, 117, 247–254.
25. Mashuni, M., Ahmad, L. O., Sandalayuk, E., Hamid, F. H., Jahiding, M., & Khaeri, A. M. N. (2022). Synthesis of antibacterial and biodegradable bioplastic based on shrimp skin chitosan and durian skin cellulose with the microwave assistance. Jurnal Kimia VALENSI, 8(1). https://doi.org/10.15408/jkv.v8i1.23233
26. Maslov, O. Y., Komisarenko, M. A., Kolisnyk, S. V., Golik, M. Y., Tsapko, Y. O., & Akhmedov, E. Y. (2022). Determination of the extraction frequency of green tea leaves by the antioxidant method. Journal of Organic and Pharmaceutical Chemistry, 20(1 (77)), 28–34.
27. Ministry of Natural Resources and Environment. Proposal No. 97/TTr-BTNMT Dated December 25, 2019 Approving the Project on Strengthening Plastic Waste Management in Vietnam; Ministry of Natural Resources and Environment: Bangkok, Thailand, 2019.
28. Musial, C., Kuban–Jankowska, A., & Gorska–Ponikowska, M. (2020). Beneficial properties of green tea catechins. International Journal of Molecular Sciences, 21(5), 1744. https://doi.org/10.3390/ijms21051744
29. Negrete-Bolagay, D., & Guerrero, C. (2024). Opportunities and challenges in the application of bioplastics: Perspectives from formulation, processing, and performance. Polymers, 16(18), 2561. https://doi.org/10.3390/polym16182561
30. Percot, A., Viton, C., & Domard, A. (2003). Optimization of chitin extraction from shrimp shells. Biomacromolecules, 4(1), 12–18. https://pubs.acs.org/sharingguidelines
31. Priyadarshi, R., & Rhim, J. (2020). Chitosan–based biodegradable functional films for food packaging applications. Innovative Food Science & Emerging Technologies, 62, 102346. https://doi.org/10.1016/j.ifset.2020.102346
32. Rahayu, D. P., De Mori, A., Yusuf, R., Draheim, R., Lalatsa, A., & Roldo, M. (2022). Enhancing the antibacterial effect of chitosan to combat orthopaedic implant-associated infections. Carbohydrate Polymers, 289, 119385. https://doi.org/10.1016/j.carbpol.2022.119385
33. Rai, S., Dutta, P. K., & Mehrotra, G. K. (2017). Lignin incorporated antimicrobial chitosan film for food packaging application. ResearchGate. https://www.researchgate.net/publication/318835566_Lignin_incorporated_antimicrobial_chitosan_film_for_food_packaging_application
34. Sree, K. P., Sree, M. S., & Samreen, P. S. (2020). Application of chitosan edible coating for preservation of tomato. International journal of chemical studies, 8(4), 3281–3285.
35. Thoene, M., Dzika, E., Gonkowski, S., & Wojtkiewicz, J. (2020). Bisphenol S in food causes hormonal and obesogenic effects comparable to or worse than bisphenol A: a literature review. Nutrients, 12(2), 532. https://doi.org/10.3390/nu12020532
36. Tran, T.H. Research and survey the status of plastic waste in Vietnam. In Report of the WWF Organization 2020; (In Vietnamese).
37. Westlake, J. R., Laabei, M., Jiang, Y., Yew, W. C., Smith, D. L., Burrows, A. D., & Xie, M. (2023). Vanillin cross-linked chitosan film with controlled release of green tea polyphenols for active food packaging. ACS Food Science & Technology, 3(10), 1680-1693. https://doi.org/10.1021/acsfoodscitech.3c00222
38. Xiong, A., Ruan, L., Ye, K., Huang, Z., & Yu, C. (2023). Extraction of chitin from black soldier fly (Hermetia illucens) and its puparium by using biological treatment. Life, 13(7), 1424. https://doi.org/10.3390/life13071424
39. Yang, C., Lu, J. H., Xu, M. T., Shi, X. C., Song, Z. W., Chen, T. M., ... & Wang, S. Y. (2022). Evaluation of chitosan coatings enriched with turmeric and green tea extracts on postharvest preservation of strawberries. Lwt, 163, 113551.
40. Yun D., Qin Y., Zhang J. et al (2021). Development of chitosan films incorporated with rambutan (Nephelium lappaceum L.) peel extract and the application in pork preservation. International Journal of Biological Macromolecules, 189,900–909.
41.Zhang X., Ismail B. B., Cheng H. et al (2021). Emerging chitosan–essential oil films and coatings for food preservation–A review of advances and applications. Carbohydrate Polymers, 2TS, 118616.